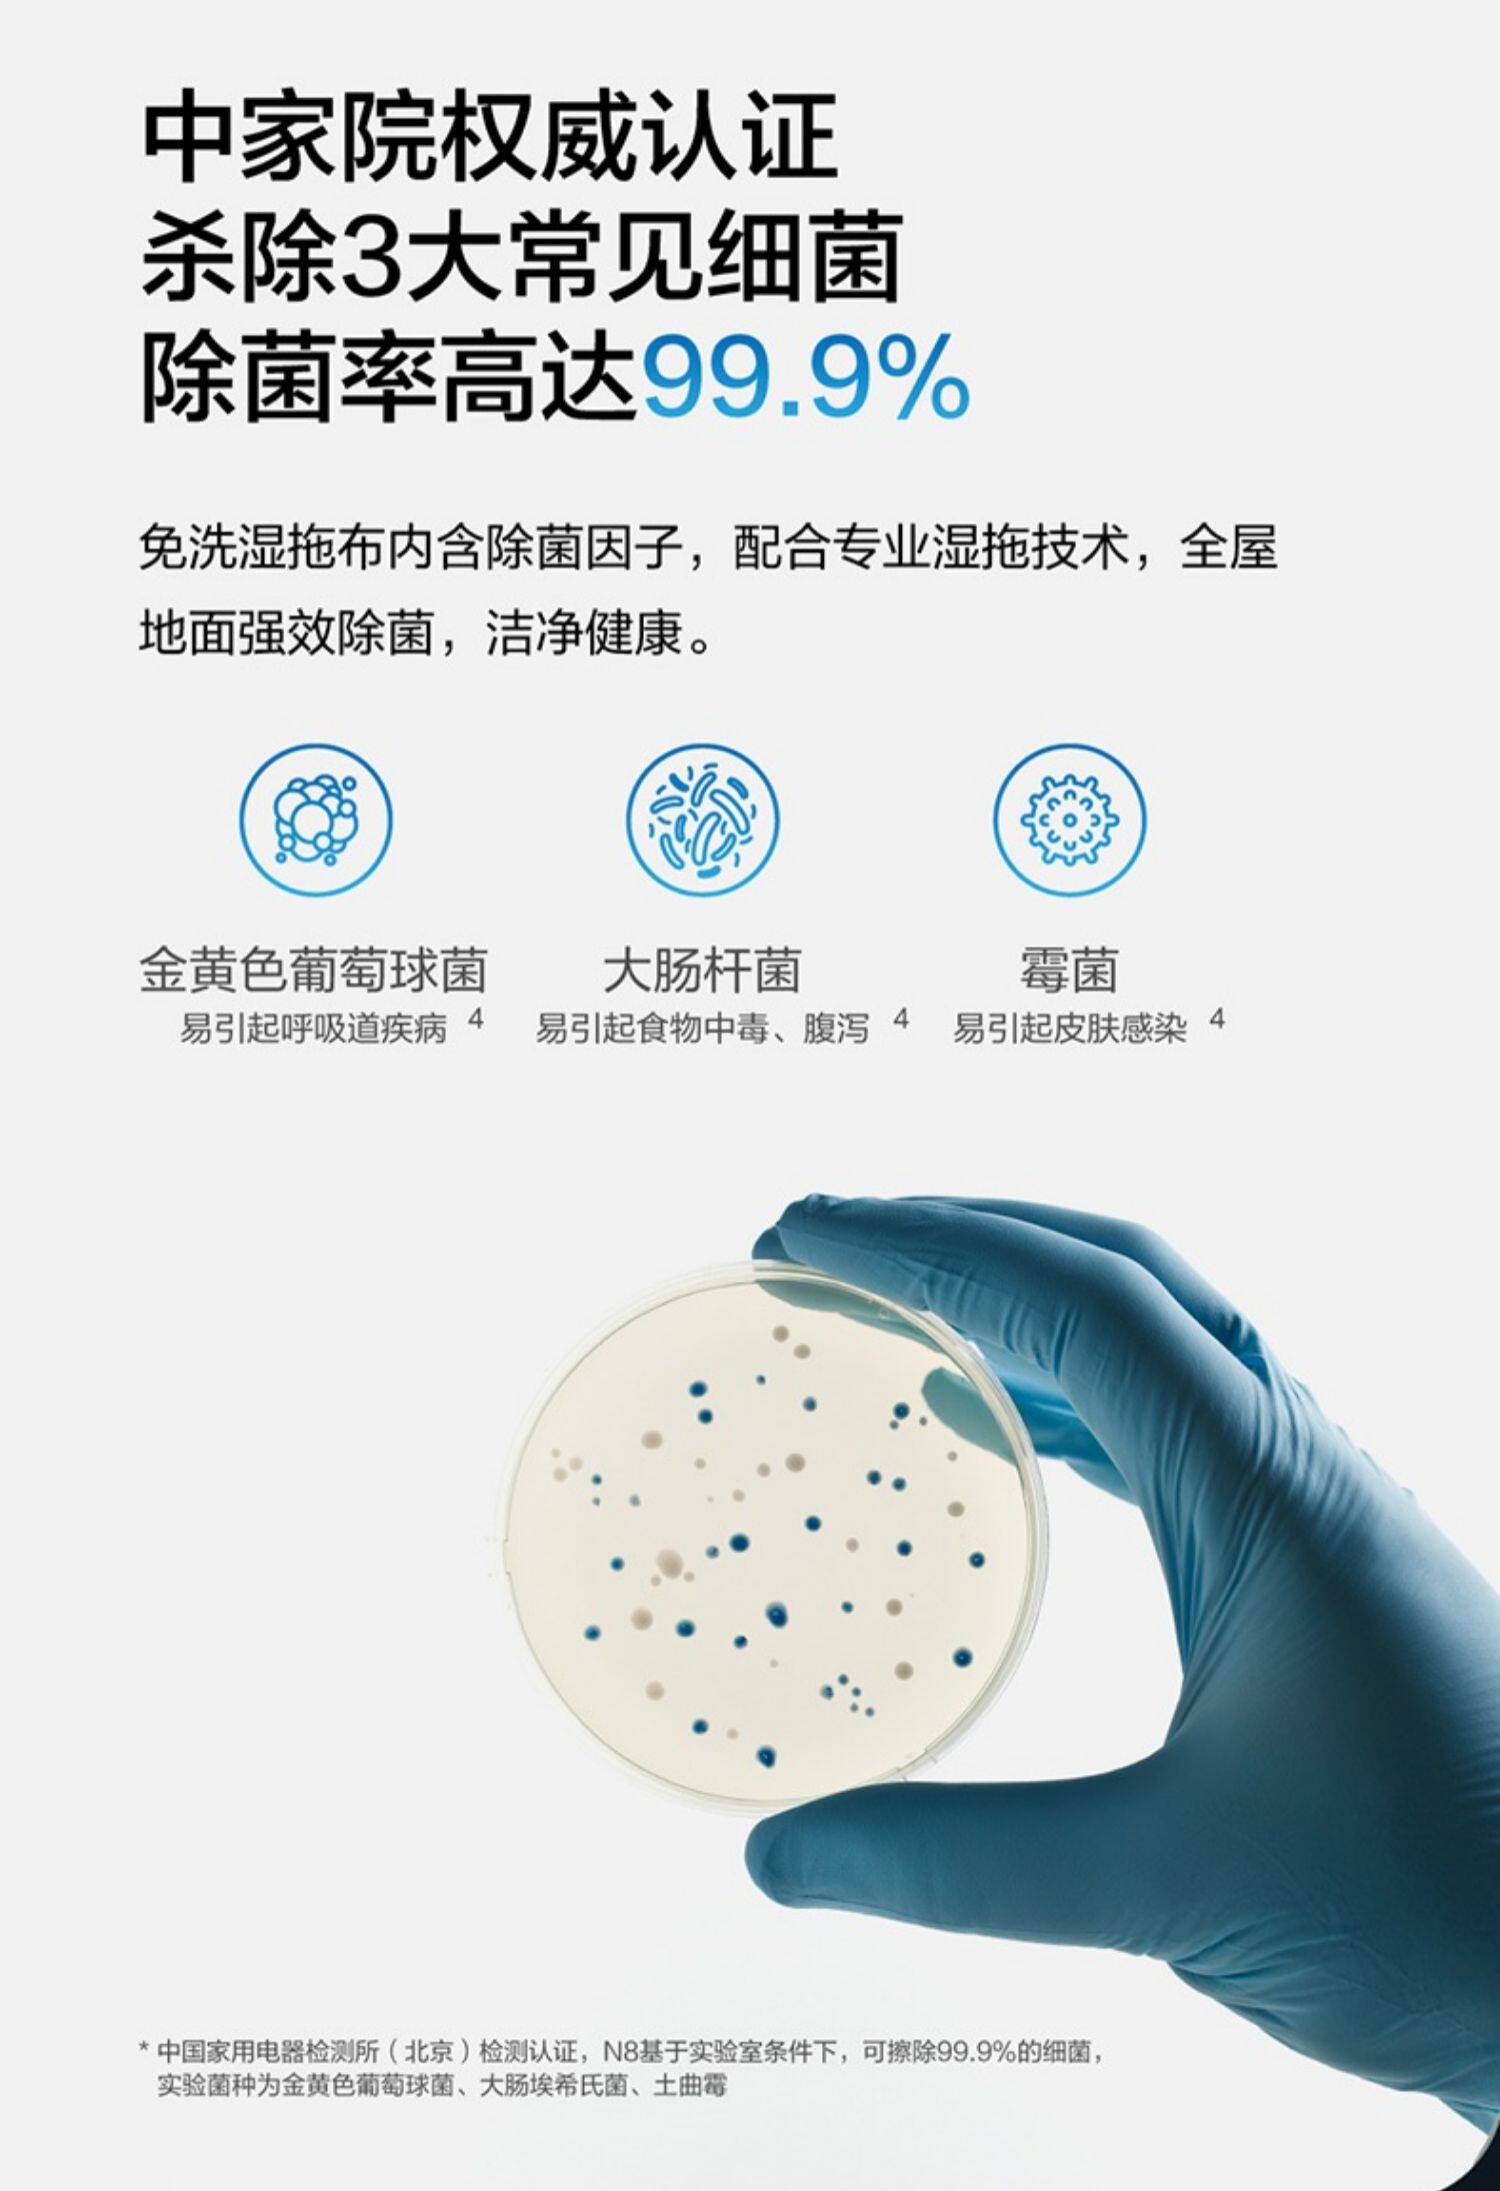

- Таобао
- Техника
- Бытовая техника
- Электрические щетки для уборки
- 693113693743
Cobos N8 Scan Robot Dibao Full Wipe Smoil Поглощение и драг -машина Deebot

Цена: 40 874руб. (¥1952.87)
Артикул: 693113693743
Вес товара: ~0.7 кг. Указан усредненный вес, который может отличаться от фактического. Не включен в цену, оплачивается при получении.
Описание товараPGRpdj48aW1nIHNyYz0iaHR0cHM6Ly9pbWcuYWxpY2RuLmNvbS9pbWdleHRyYS9pNC8yMjAwNjk0NjE0NTIwL08xQ04wMWJKZWRlQjFqR0QwYm5ITXNIXyEhMjIwMDY5NDYxNDUyMC5qcGciIGFsdD0iIj48L2Rpdj48ZGl2PjxpbWcgc3JjPSJodHRwczovL2ltZy5hbGljZG4uY29tL2ltZ2V4dHJhL2kyLzIyMDA2OTQ2MTQ1MjAvTzFDTjAxM2FkUE5jMWpHRDFmUnlka3NfISEyMjAwNjk0NjE0NTIwLmpwZyIgYWx0PSIiPjwvZGl2PjxkaXY+PGltZyBzcmM9Imh0dHBzOi8vaW1nLmFsaWNkbi5jb20vaW1nZXh0cmEvaTQvMjIwMDY5NDYxNDUyMC9PMUNOMDFWcHhxTHExakdEMWkyaGJ4UF8hITIyMDA2OTQ2MTQ1MjAuanBnIiBhbHQ9IiI+PC9kaXY+PGRpdj48aW1nIHNyYz0iaHR0cHM6Ly9pbWcuYWxpY2RuLmNvbS9pbWdleHRyYS9pMS8yMjAwNjk0NjE0NTIwL08xQ04wMTltSVNwbTFqR0QweG9mSUppXyEhMjIwMDY5NDYxNDUyMC5qcGciIGFsdD0iIj48L2Rpdj48ZGl2PjxpbWcgc3JjPSJodHRwczovL2ltZy5hbGljZG4uY29tL2ltZ2V4dHJhL2k0LzIyMDA2OTQ2MTQ1MjAvTzFDTjAxbkVrdmxPMWpHRDB1cFRjczNfISEyMjAwNjk0NjE0NTIwLmpwZyIgYWx0PSIiPjwvZGl2PjxkaXY+PGltZyBzcmM9Imh0dHBzOi8vaW1nLmFsaWNkbi5jb20vaW1nZXh0cmEvaTEvMjIwMDY5NDYxNDUyMC9PMUNOMDFFd2IyZWYxakdEMXpJN1A0WF8hITIyMDA2OTQ2MTQ1MjAuanBnIiBhbHQ9IiI+PC9kaXY+PGRpdj48aW1nIHNyYz0iaHR0cHM6Ly9pbWcuYWxpY2RuLmNvbS9pbWdleHRyYS9pNC8yMjAwNjk0NjE0NTIwL08xQ04wMVZOWWhnNjFqR0Qxd21MUlgzXyEhMjIwMDY5NDYxNDUyMC5qcGciIGFsdD0iIj48L2Rpdj48ZGl2PjxpbWcgc3JjPSJodHRwczovL2ltZy5hbGljZG4uY29tL2ltZ2V4dHJhL2kzLzIyMDA2OTQ2MTQ1MjAvTzFDTjAxNU1pNUVsMWpHRDFyUk1KblNfISEyMjAwNjk0NjE0NTIwLmpwZyIgYWx0PSIiPjwvZGl2PjxkaXY+PGltZyBzcmM9Imh0dHBzOi8vaW1nLmFsaWNkbi5jb20vaW1nZXh0cmEvaTEvMjIwMDY5NDYxNDUyMC9PMUNOMDFCZnlHSFMxakdEMjF1Q2N4cl8hITIyMDA2OTQ2MTQ1MjAuanBnIiBhbHQ9IiI+PC9kaXY+PGRpdj48aW1nIHNyYz0iaHR0cHM6Ly9pbWcuYWxpY2RuLmNvbS9pbWdleHRyYS9pNC8yMjAwNjk0NjE0NTIwL08xQ04wMWhXWDdieDFqR0QxdTFtdFJKXyEhMjIwMDY5NDYxNDUyMC5qcGciIGFsdD0iIj48L2Rpdj48ZGl2PjxpbWcgc3JjPSJodHRwczovL2ltZy5hbGljZG4uY29tL2ltZ2V4dHJhL2k0LzIyMDA2OTQ2MTQ1MjAvTzFDTjAxbmZFY2x4MWpHRDF3bUtkZDhfISEyMjAwNjk0NjE0NTIwLmpwZyIgYWx0PSIiPjwvZGl2PjxkaXY+PGltZyBzcmM9Imh0dHBzOi8vaW1nLmFsaWNkbi5jb20vaW1nZXh0cmEvaTQvMjIwMDY5NDYxNDUyMC9PMUNOMDFIVWhhM1gxakdEMXhZN1R0aF8hITIyMDA2OTQ2MTQ1MjAuanBnIiBhbHQ9IiI+PC9kaXY+PGRpdj48aW1nIHNyYz0iaHR0cHM6Ly9pbWcuYWxpY2RuLmNvbS9pbWdleHRyYS9pNC8yMjAwNjk0NjE0NTIwL08xQ04wMUkybTJ4NzFqR0QxcExFdUwyXyEhMjIwMDY5NDYxNDUyMC5qcGciIGFsdD0iIj48L2Rpdj48ZGl2PjxpbWcgc3JjPSJodHRwczovL2ltZy5hbGljZG4uY29tL2ltZ2V4dHJhL2k0LzIyMDA2OTQ2MTQ1MjAvTzFDTjAxSGx0aUlrMWpHRDF3bUt5UWhfISEyMjAwNjk0NjE0NTIwLmpwZyIgYWx0PSIiPjwvZGl2PjxkaXY+PGltZyBzcmM9Imh0dHBzOi8vaW1nLmFsaWNkbi5jb20vaW1nZXh0cmEvaTIvMjIwMDY5NDYxNDUyMC9PMUNOMDFLMlFwWGYxakdEMXRnaEZQeF8hITIyMDA2OTQ2MTQ1MjAuanBnIiBhbHQ9IiI+PC9kaXY+PGRpdj48aW1nIHNyYz0iaHR0cHM6Ly9pbWcuYWxpY2RuLmNvbS9pbWdleHRyYS9pNC8yMjAwNjk0NjE0NTIwL08xQ04wMW4xNzdSUjFqR0QxeFk4Y2FGXyEhMjIwMDY5NDYxNDUyMC5qcGciIGFsdD0iIj48L2Rpdj48ZGl2PjxpbWcgc3JjPSJodHRwczovL2ltZy5hbGljZG4uY29tL2ltZ2V4dHJhL2k0LzIyMDA2OTQ2MTQ1MjAvTzFDTjAxRkFya2U2MWpHRDF4WTY4bGhfISEyMjAwNjk0NjE0NTIwLmpwZyIgYWx0PSIiPjwvZGl2PjxkaXY+PGltZyBzcmM9Imh0dHBzOi8vaW1nLmFsaWNkbi5jb20vaW1nZXh0cmEvaTMvMjIwMDY5NDYxNDUyMC9PMUNOMDFFeDhkV2YxakdEMWtlbGkwM18hITIyMDA2OTQ2MTQ1MjAuanBnIiBhbHQ9IiI+PC9kaXY+PGRpdj48aW1nIHNyYz0iaHR0cHM6Ly9pbWcuYWxpY2RuLmNvbS9pbWdleHRyYS9pMi8yMjAwNjk0NjE0NTIwL08xQ04wMWoyUGx4RjFqR0Qxenh1M2J5XyEhMjIwMDY5NDYxNDUyMC5qcGciIGFsdD0iIj48L2Rpdj48ZGl2PjxpbWcgc3JjPSJodHRwczovL2ltZy5hbGljZG4uY29tL2ltZ2V4dHJhL2kzLzIyMDA2OTQ2MTQ1MjAvTzFDTjAxZ2tDTEptMWpHRDF6eHVuT0NfISEyMjAwNjk0NjE0NTIwLmpwZyIgYWx0PSIiPjwvZGl2PjxkaXY+PGltZyBzcmM9Imh0dHBzOi8vaW1nLmFsaWNkbi5jb20vaW1nZXh0cmEvaTQvMjIwMDY5NDYxNDUyMC9PMUNOMDFYWThaTFMxakdEMXhZNkxGaV8hITIyMDA2OTQ2MTQ1MjAuanBnIiBhbHQ9IiI+PC9kaXY+PGRpdj48aW1nIHNyYz0iaHR0cHM6Ly9pbWcuYWxpY2RuLmNvbS9pbWdleHRyYS9pNC8yMjAwNjk0NjE0NTIwL08xQ04wMVdLYlNVRzFqR0Qxa2VtTlpUXyEhMjIwMDY5NDYxNDUyMC5qcGciIGFsdD0iIj48L2Rpdj48ZGl2PjxpbWcgc3JjPSJodHRwczovL2ltZy5hbGljZG4uY29tL2ltZ2V4dHJhL2kzLzIyMDA2OTQ2MTQ1MjAvTzFDTjAxU0JwVnFuMWpHRDFxaXVhRllfISEyMjAwNjk0NjE0NTIwLmpwZyIgYWx0PSIiPjwvZGl2PjxkaXY+PGltZyBzcmM9Imh0dHBzOi8vaW1nLmFsaWNkbi5jb20vaW1nZXh0cmEvaTEvMjIwMDY5NDYxNDUyMC9PMUNOMDFJaHFkdFUxakdEMXZBOURyT18hITIyMDA2OTQ2MTQ1MjAuanBnIiBhbHQ9IiI+PC9kaXY+PGRpdj48aW1nIHNyYz0iaHR0cHM6Ly9pbWcuYWxpY2RuLmNvbS9pbWdleHRyYS9pNC8yMjAwNjk0NjE0NTIwL08xQ04wMUVwTkpubzFqR0QwdktWS1BkXyEhMjIwMDY5NDYxNDUyMC5qcGciIGFsdD0iIj48L2Rpdj4=
Продавец:启首数码旗舰店
Адрес:Чжэцзян
Рейтинг:

Всего отзывов:0
Положительных:0
Выберите вариацию / цвет
Добавить в корзину
- Информация о товаре
- Фотографии
| Цвет: | Белый |